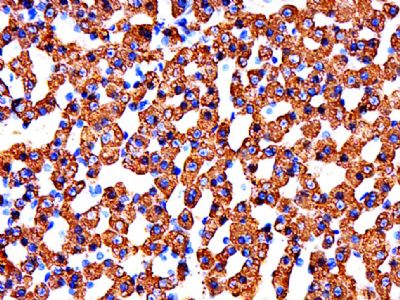
产品细节图片2

相关产品推荐更多 >
万千商家帮你免费找货
0 人在求购买到急需产品
- 详细信息
- 文献和实验
- 技术资料
- 供应商:
上海联迈生物工程有限公司
- 库存:
大量
- 目录编号:
LM-10099R
- 克隆性:
多克隆
- 抗原来源:
Rabbit
- 保质期:
1年
- 抗体英文名:
CYP11A1
- 抗体名:
细胞色素P450 11A1抗体
- 宿主:
Rabbit
- 适应物种:
Human, Mouse, Rat, Dog, Pig, Cow, Horse, Rabbit, Sheep, 53/57
- 免疫原:
KLH conjugated synthetic peptide derived from human CYP11A1/P450SCC:41-140/521
- 亚型:
IgG
- 形态:
Lyophilized or Liquid
- 应用范围:
WB=1:500-2000 ELISA=1:500-1000 IHC-P=1:400-800 IHC-F=1:400-800 Flow-Cyt=1μg/Test ICC=1:100-500 IF=1:100-500 (石蜡切片需做抗原修复)
- 浓度:
1mg/ml
- 保存条件:
Store at -20 °C
- 规格:
50ul 100ul 200ul
| 英文名称 | CYP11A1 |
| 中文名称 | 细胞色素P450 11A1抗体 |
| 别 名 | Cholesterol 20 22 desmolase; Cholesterol desmolase; Cholesterol monooxygenase (side chain cleaving); Cholesterol side chain cleavage enzyme; Cholesterol side chain cleavage enzyme mitochondrial; Cholesterol side-chain cleavage enzyme; CP11A_HUMAN; CYP11A; CYPXIA1; Cytochrome P450 11A1; Cytochrome P450 11A1 mitochondrial; Cytochrome P450 family 11 subfamily A polypeptide 1; Cytochrome P450 subfamily XIA; Cytochrome P450(scc); Cytochrome P450C11A1; mitochondrial; P450SCC; Steroid 20 22 lyase |
| 规格价格 | 50ul/780元 购买 100ul/1380元 购买 200ul/2200元 购买 大包装/询价 |
| 说 明 书 | 50ul 100ul 200ul |
| 研究领域 | 肿瘤 细胞生物 免疫学 转录调节因子 线粒体 |
| 抗体来源 | Rabbit |
| 克隆类型 | Polyclonal |
| 交叉反应 | Human, Mouse, Rat, Dog, Pig, Cow, Horse, Rabbit, Sheep, 53/57 |
| 产品应用 | WB=1:500-2000 ELISA=1:500-1000 IHC-P=1:400-800 IHC-F=1:400-800 Flow-Cyt=1μg/Test ICC=1:100-500 IF=1:100-500 (石蜡切片需做抗原修复) not yet tested in other applications. optimal dilutions/concentrations should be determined by the end user. |
| 分 子 量 | 53/57kDa |
| 细胞定位 | 细胞浆 细胞膜 线粒体 |
| 性 状 | Lyophilized or Liquid |
| 浓 度 | 1mg/ml |
| 免 疫 原 | KLH conjugated synthetic peptide derived from human CYP11A1/P450SCC:41-140/521 |
| 亚 型 | IgG |
| 纯化方法 | affinity purified by Protein A |
| 储 存 液 | 0.01M TBS(pH7.4) with 1% BSA, 0.03% Proclin300 and 50% Glycerol. |
| 保存条件 | Store at -20 °C for one year. Avoid repeated freeze/thaw cycles. The lyophilized antibody is stable at room temperature for at least one month and for greater than a year when kept at -20°C. When reconstituted in sterile pH 7.4 0.01M PBS or diluent of antibody the antibody is stable for at least two weeks at 2-4 °C. |
| PubMed | PubMed |
| 产品介绍 | background: This gene encodes a member of the cytochrome P450 superfamily of enzymes. The cytochrome P450 proteins are monooxygenases which catalyze many reactions involved in drug metabolism and synthesis of cholesterol, steroids and other lipids. This protein localizes to the mitochondrial inner membrane and catalyzes the conversion of cholesterol to pregnenolone, the first and rate-limiting step in the synthesis of the steroid hormones. Two transcript variants encoding different isoforms have been found for this gene. The cellular location of the smaller isoform is unclear since it lacks the mitochondrial-targeting transit peptide. [provided by RefSeq, Jul 2008] Function: Catalyzes the side-chain cleavage reaction of cholesterol to pregnenolone. Subcellular Location: Mitochondrion membrane. DISEASE: Defects in CYP11A1 are the cause of adrenal insufficiency congenital with 46,XY sex reversal (AICSR) [MIM:613743]. A rare disorder that can present as acute adrenal insufficiency in infancy or childhood. ACTH and plasma renin activity are elevated and adrenal steroids are inappropriately low or absent; the 46,XY patients have female external genitalia, sometimes with clitoromegaly. The phenotypic spectrum ranges from prematurity, complete underandrogenization, and severe early-onset adrenal failure to term birth with clitoromegaly and later-onset adrenal failure. Patients with congenital adrenal insufficiency do not manifest the massive adrenal enlargement typical of congenital lipoid adrenal hyperplasia. Similarity: Belongs to the cytochrome P450 family. SWISS: P05108 Gene ID: 1583 Database links: Entrez Gene: 1583 Human Entrez Gene: 13070 Mouse Entrez Gene: 29680 Rat Omim: 118485 Human SwissProt: Q2XV99 Cynomolgus Monkey SwissProt: P05108 Human SwissProt: Q9QZ82 Mouse SwissProt: P14137 Rat Unigene: 303980 Human Unigene: 302865 Mouse Unigene: 1401 Rat Important Note: This product as supplied is intended for research use only, not for use in human, therapeutic or diagnostic applications. |
| 产品图片 | ![]() Sample:Testis(Mouse)Lysate at 40 ug Primary: Anti-CYP11A1(bs-10099R)at 1/300 dilution Secondary: IRDye800CW Goat Anti-Rabbit IgG at 1/20000 dilution Predicted band size: 53/57 kD Observed band size: 53/57 kD ![]() Paraformaldehyde-fixed, paraffin embedded (mouse adrenal gland); Antigen retrieval by boiling in sodium citrate buffer (pH6.0) for 15min; Block endogenous peroxidase by 3% hydrogen peroxide for 20 minutes; Blocking buffer (normal goat serum) at 37°C for 30min; Antibody incubation with (Cytochrome P450 family 11 subfamily A polypeptide 1) Polyclonal Antibody, Unconjugated (bs-10099R) at 1:500 overnight at 4°C, followed by a conjugated secondary (sp-0023) for 20 minutes and DAB staining. ![]() Paraformaldehyde-fixed, paraffin embedded (human liver carcinoma); Antigen retrieval by boiling in sodium citrate buffer (pH6.0) for 15min; Block endogenous peroxidase by 3% hydrogen peroxide for 20 minutes; Blocking buffer (normal goat serum) at 37°C for 30min; Antibody incubation with (Cytochrome P450 family 11 subfamily A polypeptide 1) Polyclonal Antibody, Unconjugated (bs-10099R) at 1:500 overnight at 4°C, followed by a conjugated secondary (sp-0023) for 20 minutes and DAB staining. ![]() Cell: HepG2. Concentration:1:100 Host/Isotype:Rabbit/IgG Flow cytometric analysis of Rabbit IgG isotype control (Cat#: bs-10099R) on HepG2(green) compared with control in the absence of primary antibody (blue) followed by Alexa Fluor 488-conjugated goat anti-rabbit IgG(H+L) secondary antibody . |
风险提示:丁香通仅作为第三方平台,为商家信息发布提供平台空间。用户咨询产品时请注意保护个人信息及财产安全,合理判断,谨慎选购商品,商家和用户对交易行为负责。对于医疗器械类产品,请先查证核实企业经营资质和医疗器械产品注册证情况。
文献和实验小鼠细胞色素P450(Cytochrome P450)ELISA试剂盒 说明书
上海西唐生物科技有限公司 021-55229872, 65333639 www.westang.com 小鼠细胞色素P450 ( Cytochrome P450 )ELISA 试剂盒 原理 本实验采用双抗体夹心 ABC-ELISA 法。用抗小鼠 Cytochrome P450 单抗包被于酶标板上,标准品和样品中的 Cytochrome P450与单抗结合,加入生物素化的抗小鼠
存在于很多细胞的微粒体和副肾皮质的线粒体里的一种血红蛋白质,也简称 P- 450( p是色素 pigment的缩写)。在还原状态,和 CO牢固结合,形成在 450毫微米处最大的吸收光谱。如与膜结合进行可溶化,就变成最大吸收在 420毫微米处的 CO结合物的 P- 420的物质。 P- 450能自动氧化,通过分子态氧催化类固醇和芳香族胺等羟基化反应。这时需要 NADPH。它是经过一种黄素酶和铁氧还原蛋白( ferredoxin)一样的物质,在副肾皮质里是皮质铁氧
抗体的结构决定了其对应的功能,同一抗体的V区和C区的氨基酸组成和顺序不同,决定了其功能上的差异。V区和C区的组成和结构,决定了抗体的生物学功能。 图1:抗体的主要功能(图片来源:Abbas et al: Cellular and Molecular Immunology, 7e.) 1、特异性识别功能 抗体可以通过其结构上的可变区域与抗原结合,同时,具有极高的特异性。这种特异性识别功能可以使抗体识别和结合到感染的病原体,肿瘤细胞等不同种类的分子,帮助免疫系统识别并定位到这些分子,进而启动
技术资料暂无技术资料 索取技术资料